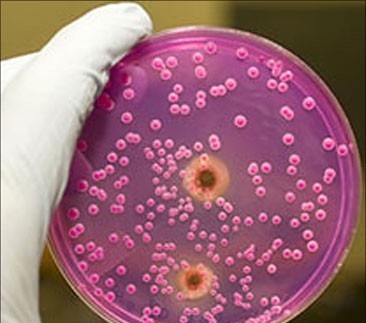
Фавус

Фавус (парша, волчий лишай) - это хроническая инфекция грибкового генеза, поражающая кожу волосистой части головы, гладкую кожу, ногти, волосы, реже - внутренние органы. Распространена данная патология повсеместно. Дети заболевают несколько чаще взрослых, женщины чаще мужчин.

Причины возникновения
Возбудителем данной грибковой инфекции является Trichophyton schonleinii - антропофильный грибок. Основной механизм передачи инфекции - контактно-бытовой (тесный контакт с больным, его личными вещами, одеждой, посудой). Фавус не относится к заболеваниям с высокой контагиозностью, потому для инфицирования недостаточно лишь контакта с инфицированным человеком или его вещами. Входные ворота инфекции - микротравмы, травмы кожного покрова. Предрасполагающими факторами для заболевания данным микозом являются такие эндогенные факторы, как эндокринологические болезни (гипотиреоз, сахарный диабет и др.), хронические соматические заболевания, интоксикации, авитаминозы, длительный приём глюкокортикостероидов, ослабление иммунитета, иммунодефицитные состояния, приём иммуносупрессоров и цитостатиков, гиповитаминозы, воздействие на организм ионизирующего излучения (профессиональная вредность, лучевая терапия при опухолях и т.п.), а также экзогенные факторы - порезы, ссадины, ожоги, глубокие травмы с повреждением кожных покровов.
Симптомы фавуса

Инкубационный период при данном заболевании составляет от 2 до 3 недель. В большинстве случаев поражается волосистая часть головы, в четверти случаев - ногтевые пластинки. Остальные локализации поражения встречаются редко. Основным клиническим признаком фавуса является возникновение блюдцеобразных сухих корок желтовато-коричневатого цвета с углублением в середине (скутула). Волосы на поражённых участках кожи выпадают (в отличие от других грибковых поражений этой области), развиваются рубцовые и атрофические изменения поражённой кожи. Для сквамозной формы фавуса характерно также шелушение крупными чешуйками, похожими на перхоть. Слизистые оболочки, лимфатические узлы и внутренние органы поражаются, как правило, при тяжёлых нарушениях работы иммунной системы. В наиболее тяжёлых случаях могут развиваться менингоэнцефалиты грибковой природы и эрозивно-язвенные дефекты желудочно-кишечного тракта. Ногти поражаются зачастую при аутоинфицировании (расчесывании кожи головы). При этом ногти, как правило, не деформируются (форма ногтя остаётся прежней, но толщина может увеличиваться), однако их цвет может меняться. Для импетигиозной формы фавуса характерно образование заполненных гноем пузырьков, покрытых желтыми корками.
Диагностика
При диагностике фавуса, в первую очередь, проводят микроскопическое исследование соскоба кожи, частиц скутул, волос и ногтевых пластинок (обнаруживается мицелий гриба и его споры). Проводят также посев на питательные среды (культуральное исследование). Колония грибов начинает расти к 5-10 дню, имеет морщинистый вид и желтоватый окрас. При отсутствии роста колонии на протяжении одного месяца и более считается, что материал не инфицирован данным видом грибка. Дополнительными методами диагностики являются люминисцентный метод осмотра при помощи лампы Вуда (отмечается зеленоватое свечение поражённых грибком участков), а также дерматоскопический метод исследования.
Классификация
В зависимости от локализации грибкового поражения различают фавус волосистой части головы, гладкой кожи, ногтей, а также внутренних органов.
По характеру патологического процесса выделяют следующие формы фавуса:
·классическая (скутулярная) форма;
·импетигиозная форма;
·сквамозная форма фавуса.
Действия пациента
При возникновении каких-либо симптомов, указанных в соответствующем разделе, следует обратиться к врачу-микологу и обследоваться с целью максимально раннего начала лечения во избежание развития осложнений и поражения внутренних органов.
Лечение фавуса
В качестве этиотропного лечения применяются противогрибковые средства (как системно, так и местно, то есть наружно). Местно применяют кремы и мази (кетоконазол, итраконазол, клотримазол, йод, салициловую кислоту, анилиновые красители и т.п.), а также сбривают волосы каждую неделю до полного выздоровления (как минимум три отрицательных микроскопических исследований). При серьёзных поражениях ногтя хирургически удаляют ногтевую пластинку. Кроме того, важно проводить иммуномодулирующую терапию.
Осложнения
Осложнениями фавуса могут становиться рубцовые изменения поражённых ранее участков, облысение, а также поражение внутренних органов.
Профилактика фавуса
Первичной профилактикой фавуса является соблюдение правил личной гигиены. Вторичная профилактика заболевания заключается в своевременном обнаружении инфицированных лиц и их изоляции до полного излечения, а также дезинфекция очага инфекции и осмотр лиц, контактировавших с больным.
Этот коварный грибок, или онихомикоз
